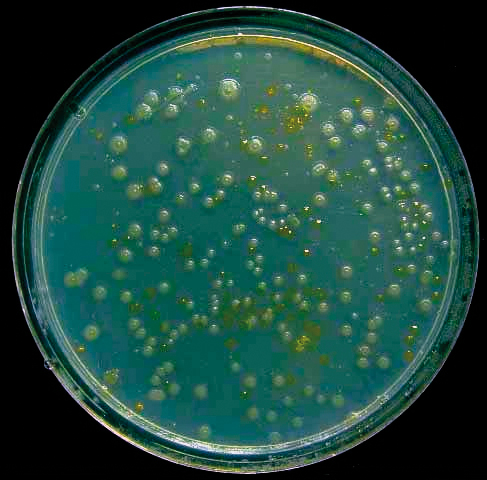
MT May 16 astrobiology miers valley bacteria

Astrobiology
I had just finished my first degree and was about to start a PhD when, in 1976, we were all gripped by the excitement of finding evidence of life on another planet. The Viking mission to Mars by NASA had experiments on board the lander that were designed to show whether there were any living organisms in the surface soil of Mars. The labelled release experiment showed a huge release of radiolabelled CO2 when 14C labelled nutrients were mixed with a sample of Martian soil.
We know now that this was probably due to the highly reactive oxidised compounds in the soil created by solar UV radiation on the Martian surface. Mars has such a thin atmosphere and no ozone layer so UV from the Sun would not be absorbed before reaching the ground. The UV reacts to form highly oxidised chemicals that would break down the nutrients added in the Viking experiments releasing CO2.
Life on Mars?
Years later I would return to thinking about life on Mars and other planets in our Solar System when starting to do research in Astrobiology. Astrobiology is the study of life in the universe and also its origins here on Earth. It also investigates life in extreme environments on Earth such as extremely cold, dry habitats like the Antarctic dry valleys, hot, dry desert environments such as the Namib or Atacama Deserts and volcanic-associated vents on land and in the deep ocean. Microbes are the organisms that astrobiologists are primarily interested in and it was in these extreme environments that the Archaea were first found. It’s a salutary lesson to us as microbiologists that it was only recently in 2002 that we discovered the most abundant free-living organism on Earth. This is the bacterium Pelagibacter ubique SAR11 and there are estimated to be 2.4x1028 SAR11 cells in the world’s oceans. Often we fail to see what is there in front of us because of our fixed understanding of what we should be looking for.
Mars–Earth history
Mars is small, a little more than half the diameter of Earth. In the history of formation of the Solar System when all the planetary bodies were being formed by accretion of material around the proto-Sun, Mars being smaller than Earth would have cooled more quickly. If the conditions for life are liquid water, protection from damaging radiation, and nutrients and energy, then Mars would have had these conditions before Earth. The Earth is thought to have cooled at about 3.9 billion years (G yr) before present (BP). Mars could have cooled to have liquid water and an atmosphere as dense as the current Earth by about 4 G yr BP. The first evidence for life on Earth is about 3.8 G year BP and there is good geological evidence for large amounts of material blasted off the surface of Mars by asteroid impacts raining down on Earth in those early days of the Solar System. So there is the possibility that microbial life, if it had evolved on Mars during those 200 million years, could have been carried from the surface of Mars by asteroid impacts and been deposited on Earth, possibly helping or kick-starting life on Earth.
The mass of Mars is about 10 times less than that of Earth and the gravity on Mars is 38% that of Earth. Mars also lost its magnetic field about 4 G yr BP and a consequence of the low gravity and lack of magnetic field is that Mars would have started to lose its atmosphere soon after it formed. The solar wind exerts a constant stripping pressure on a planet’s outer atmosphere and a strong magnetic field, such as the one on Earth, prevents charged particles from the Sun stripping the outer layers of the atmosphere away. A dense atmosphere protects a planet’s surface from harmful solar radiation such as hard UV. Mars, unlike Earth, does not have a magnetic field, so as Mars cooled and allowed microbial life to evolve, its protective atmosphere was gradually being stripped away. The current conditions at the surface of Mars are an atmospheric pressure of only 6 mbar (Earth’s atmosphere is 1 bar, 166 times more dense than Mars) and a daytime temperature at the equator of –58°C. This is below the triple point of water so liquid water cannot exist stably at the surface.
Cosmic radiation on Mars
A second consequence of the lack of a dense atmosphere on Mars is that highly energetic charged particles from the Sun (protons) and galactic cosmic rays (mainly protons and helium nuclei) have nothing to block them until they hit the Martian surface. When these energetic particles hit Earth’s atmosphere they produce showers of secondary particles which themselves produce further energetic charged particles in a spreading cone of radiation, reaching its peak at what is called the Pfotzer (or Regener) maximum, and on Earth this Pfotzer maximum is 15 km, about 5 km above the normal cruising height of modern commercial jets. On Mars the Pfozter maximum is in the top few metres of the soil surface. Thus, not only is the Martian surface effectively sterilised by solar UV, the Martian soil to a depth of a few metres will be exposed to sufficient radiation to destroy biomolecules over a period of 0.4 to 6 million years at a depth of 5 metres. We looked at the radiation resistance of terrestrial cells such as Deinococcus radiodurans (Fig. 1) and Antarctic isolates combined with the annual radiation doses on Mars, and calculated the survival time of dormant populations of the cells. Bacteria can be radiation-resistant because, when active, they successfully repair the DNA breaks caused by ionising radiation. However, when cells are dormant, such as frozen in the subsurface of Mars, they are preserved but unable to repair radiation damage, which accumulates to the point where the cell becomes permanently inactivated.
FIG. 1. COLOURED SCANNING ELECTRON MICROGRAPH OF FOUR DEINOCOCCUS RADIODURANS BACTERIA FORMING A TETRAD.

At a 2-metre depth a radioresistant organism would have had to be reanimated to repair its DNA within the last 450,000 years to still be viable. Given that the temperature is too low for living processes at the surface we should look for evidence of life, e.g. biomolecules and microbes, at a depth below 5 metres.
Mars analogues on Earth
Astrobiologists like to hunt for bacteria and archaea on Earth in places that could be thought to be similar to at least some of the conditions on Mars. The Antarctic dry valleys at McMurdo Sound (Fig. 2) are amongst the driest and coldest places on Earth, and microbiologists have sampled these valleys to determine whether micro-organisms can survive there. There are in fact quite extensive microbial communities in the soils there and even lichens (an algae or cyanobacteria mutualism with fungi) in the surface of rocks. Plating studies of Dry Valley micro-organisms (Fig. 3) and more recently 16S ribosomal DNA metagenomics show a large range of bacteria, with Firmicutes, Proteobacteria and Actinobacteria being the main phyla in all depths of soil down to 20 cm, and the Acidobacteria, Actinobacteria, Bacteroidetes and Gammaproteobacteria more abundant in the interface with the permafrost.
FIG. 2. MIERS VALLEY, ANTARCTICA.

FIG. 3. MIERS VALLEY BACTERIA AFTER 12 WEEKS' GROWTH.
What should we look for on Mars?
If the conditions were compatible for life to evolve on Mars in those few hundred million years before conditions became too tough and possibly drove it underground, then we should be looking for bacteria or their biosignatures. We now understand that on Earth, bacteriophages, or phages (Fig. 4) – viruses that infect bacteria – outnumber bacteria by about 10 to 1. Given that phages are very tough and many can withstand conditions that their hosts cannot, I would advise looking for phages on Mars. Of course we can’t use plaque formation in soft agar to see whether phages are present because we would need a live host for each phage type – a real chicken-and-egg conundrum. But filtering a sample of Martian regolith from about 2 to 5 metres underneath the surface and using an electron microscope to search for phages might not be a bad idea.
FIG. 4. T4 PHAGE.

JOHN WARD
Department of Biochemical Engineering, University College London, Bernard Katz Building, Gordon Street, London WC1H 0AH, UK
FURTHER READING
Dartnell, L. (2007). Life in the Universe: A Beginner’s Guide, Astrobiology. Oxford: Oneworld Publications.
Dartnell, L. R. & others (2007). Martian sub-surface ionizing radiation: biosignatures and geology. Biogeosciences 4, 545–558.
Dartnell L. R. & others (2009). Desiccation resistance of Antarctic Dry Valley bacteria isolated from contrasting locations. Antarctic Sci 22, 171–172.
Dartnell L. R. & others (2010). Low-temperature ionising radiation resistance of Deinococcus radiodurans and Antarctic Dry Valley bacteria. Astrobiology 10, 717–732.
Dartnell L. R. & others (2012). Destruction of Raman biosignatures by ionising radiation and the implications for life-detection on Mars. Anal Bioanal Chem 403,131–144.
Stomeo F. & others (2012). Abiotic factors influence microbial diversity in permanently cold soil horizons of a maritime-associated Antarctic Dry Valley. FEMS Microbiol Ecol 82, 326–340.
